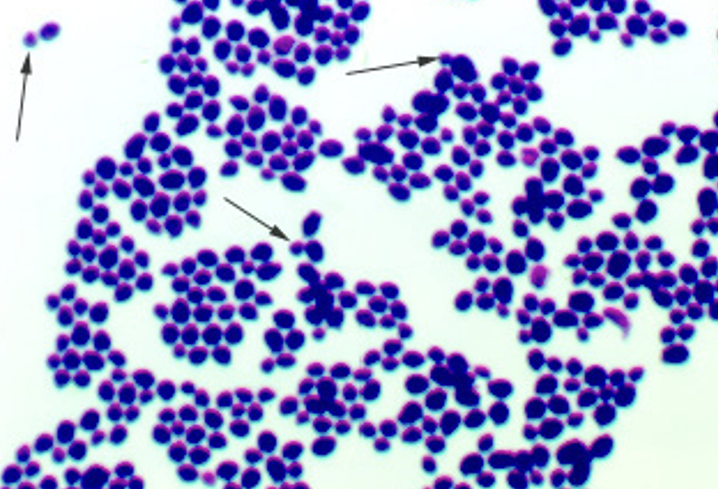
knowt flashcard image

1/36
Looks like no tags are added yet.
Name | Mastery | Learn | Test | Matching | Spaced | Call with Kai |
|---|
No analytics yet
Send a link to your students to track their progress
Trypanosoma bruceii

What diease does Trypanosoma bruceii cause?
African sleeping sickness - characterized by neurological issues
Plasmodium

What disease does Plasmodium cause
Malaria -
Giardia lamblia

What disease does Giardia lamblia cause?
Giardiasis or “Beaver fever” - characterized by foul smelling diarrhea
Entamoeba histolytica

What disease does Entamoeba histolytica cause?
Amoebiasis - characterized by diarrhea containing blood and mucus, bacteria eats intestinal tissue
Balantidium coli

What disease does Balantidium coli cause?
Balantidiasis - characterized by blood in diarrhea, abdominal pain. Pigs are primary reservoir host
Schistosoma mansoni (male)

Schistosoma mansoni (female)

Taenia pisiformis

Ascaris lumbricoides (Male)

Ascaris lumbricoides (female)

Enterobius vermicularis

What disease does Enterobius vermicularis cause?
Enterobiasis (Pinworm) - worm that crawls out of your butt to lay eggs
Ancylostoma duodenale

What disease does Ancylostoma duodenale cause?
Ancylostoma (Hookworm) - causes iron deficient anemia
Necatur americanus

Ixodes

What disease do Ixodes transmit?
Lyme disease
Amblyomma

What disease do Amblyomma transmit
Ehrlichiosis
Anopheles

What disease do Anopheles transmit
Malaria
Culex

What disease do Culex(s) transmit
Arhtropod-borne viral encephalitis
Zygospore of Rhizupus

Macroconidia of Trichophyton

Blastospore of thrush (candida)
Pseudohyphae of Candida

Liver fluke

Diphyllobothrium Latum Gravid

Taenia pisiformis

Enterobius verimcularis eggs

Trichinella spirallis encysted larvae
